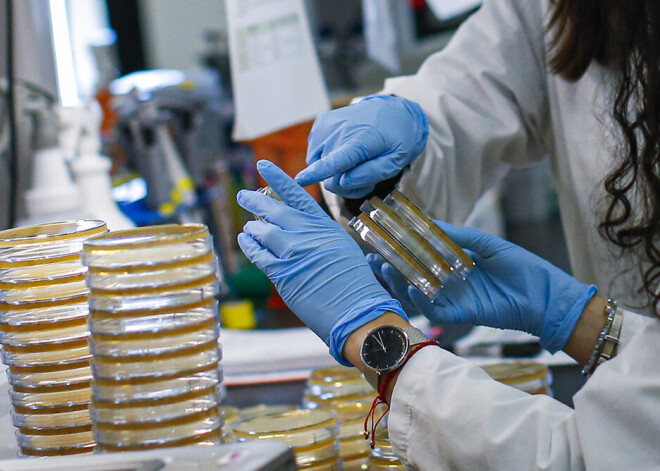

Igaunijā konstatēti vēl trīs inficētie ar koronavīrusu; kopējais inficēto skaits - 13
Igaunijas Veselības departamenta laboratorijā konstatēti vēl trīs inficējušies ar jauno koronavīrusu, līdz ar to kopējais valstī inficēto skaits palielinājies līdz 13, otrdien paziņoja Igaunijas Veselības departaments.
Divi ar Covid-19 saslimušie ir pieauguši Tallinas iedzīvotāji. Viens no viņiem atgriezies no Itālijas ziemeļiem, bet otrs - no Francijas. Trešais saslimušais ir Igaunijas pilsonis, kurš atgriezies no Itālijas ziemeļiem caur Ženēvu un Helsinkiem.
Vēl deviņi cilvēki, kuriem Igaunijā konstatēta inficēšanās ar jauno koronavīrusu, bija tikko atgriezušies no ārzemēm. Lielākā daļa bija ceļojuši caur Rīgas lidostu.
Saslimšana ar Covid-19 disgnosticēta arī kādam Tallinas Kristīnes ģimnāzijas audzēknim. Tāpēc mācības ģimnāzijas ēkā pārtrauktas vismaz uz divām nedēļām.
Pirmais saslimšanas gadījums Igaunijā tika apstiprināts 27.februārī, kad slimību diagnosticēja Irānas pilsonim, Igaunijas pastāvīgajam iedzīvotājam, kas bija ieradies Rīgā ar lidmašīnu caur Stambulu un ar autobusu devies uz Tallinu.
Latvijā Covid-19 diagnosticēts astoņiem cilvēkiem.



